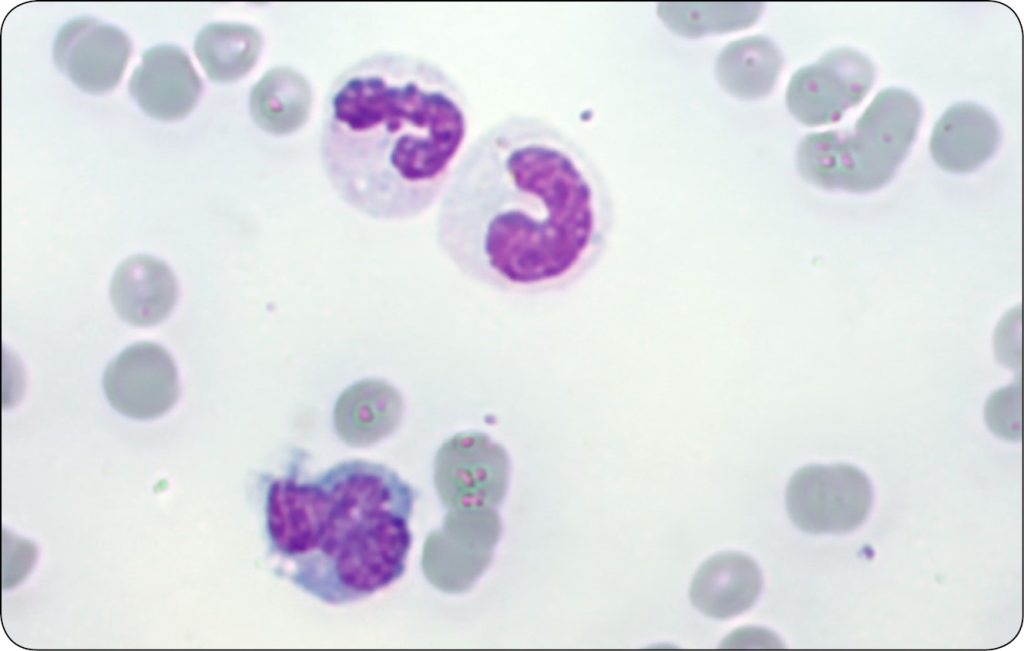
KONIE_24_Marzena_Paszkowska_KIEDY_WARTO_ZLECIC_ROZMAZ_KRWI_U_KONI_RYC_5

Kiedy warto zlecić rozmaz krwi u koni?
Aktywacja leukocytów wskazuje na pobudzenie układu immunologicznego, częste na tle stanów zapalnych, infekcji czy chorób odkleszczowych. Oczywiście u części pacjentów identyfikacja stanu zapalnego ma miejsce na podstawie badania klinicznego, morfologii krwi czy oznaczenia stężenia białek ostrej fazy. Ocena mikroskopowa leukocytów może jednak być niezastąpiona w przypadkach mniej oczywistych, jak np. neutropenia. Wykazanie przesunięcia w lewo oraz aktywacji neutrofili pozwala przypuszczać, że jej przyczyną jest stan zapalny z przesunięciem neutrofili do tkanek (a nie np. zaburzenia funkcji szpiku kostnego) (14). Podobnie wykazanie cech aktywacji neutrofili, limfocytów lub monocytów w przypadku wzrostu liczby komórek danej frakcji potwierdza odczynowy charakter zmiany (ryc. 5).
Mianem komórek atypowych w rozmazie krwi obwodowej określane są komórki o morfologii niespotykanej wśród prawidłowych komórek krwi. Cechami atypii komórkowej mogą być m.in. nieprawidłowa wielkość i kształt komórki i jądra komórkowego oraz obecność jąderek. Najczęściej są to komórki nowotworowe wywodzące się z linii leukocytarnej (chłoniak lub białaczka). Ich obecność we krwi obwodowej stwierdza się jednak dopiero w późnej fazie rozwoju procesu nowotworowego. Z tego powodu nieobecność komórek atypowych we krwi nie wyklucza występowania procesu nowotworowego toczącego się w innych tkankach.
W niektórych przypadkach morfologia komórek uniemożliwia jednoznaczne rozróżnienie między silną ich aktywacją (na tle odczynowym) a atypią (na tle nowotworowym) (5). [...]
którzy są subskrybentami naszego portalu.
i ciesz się dostępem do bazy merytorycznej wiedzy!
POSTĘPOWANIA
w weterynarii






















